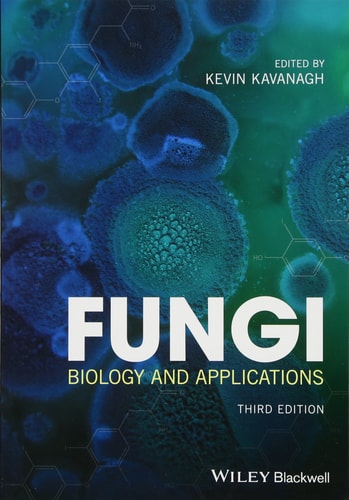

Sale!
Fungi (Biology and Applications) (3rd Edition)
Original price was: $39.99.$24.99Current price is: $24.99. $19.99
Download Fungi (Biology and Applications) (3rd Edition) written by Kevin Kavanagh (ed.) in PDF format. This book is under the category Science and bearing the isbn13 numbers 1119374324/9781119374329. You may reffer the table below for additional details of the book. We do NOT provide access codes, we provide eBooks ONLY. Instant access will be granted as soon as you complete the payment. p>
Additional information
| book-author | Kevin Kavanagh (ed.) |
|---|---|
| publisher | Wiley-Blackwell |
| file-type | |
| pages | 416 |
| language | English |
| isbn10 | 1119374324 |
| isbn13 | 9781119374329 |
| year | 2018 |
Related products
- Sale!

Drinking Water Minerals and Mineral Balance (Importance, Health Significance, Safety Precautions) (2nd Edition)
Original price was: $39.99.$24.99Current price is: $24.99.$19.99 - Sale!

Carbon Dioxide Sensing: Fundamentals; Principles; and Applications
Original price was: $39.99.$24.99Current price is: $24.99.$19.99 - Sale!

Semiconductor Optics 2 (Dynamics, High-Excitation Effects, and Basics of Applications) (5th Edition)
Original price was: $39.99.$24.99Current price is: $24.99.$19.99 - Sale!

Handbook of Plant Disease Identification and Management
Original price was: $39.99.$24.99Current price is: $24.99.$19.99